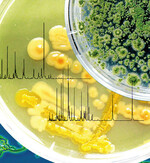
Der Diagnose-Test soll auch helfen he-
rauszufinden, ob Krankheitskeime Früch-
te und Gemüse bei Anbau, Bewässerung,
Düngung, Verarbeitung oder während der
Lagerung kontaminiert haben

Obst & Gemüse: Diagnose von Krankheitserregern
Wer Obst und Gemüse kauft, erwartet gesundheitlich bedenkenlose Frischprodukte. Um das zu gewährleisten, müssen Labors krankmachende Keime verlässlich identifizieren können.
- Veröffentlicht am
Damit dies noch schneller als bisher möglich wird, hat
die Forschungsanstalt Agroscope Changins-Wädenswil (ACW) zusammen mit dem Functional Genomics Center Zürich (FGCZ) eine neue Methode erarbeitet, auf deren Grundlage
ein einfacher Diagnose-Test für krankmachende Bakterien und Pilze (z.B.
Salmonellen oder Schimmelpilze) entwickelt werden soll.
ACW
ACW
Zu diesem Artikel liegen noch keine Kommentare vor.
Artikel kommentierenSchreiben Sie den ersten Kommentar.